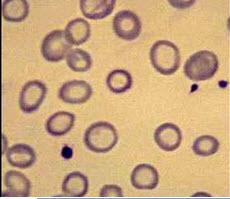

患者,男,19岁,1年前明显出现疲乏无力,伴头晕,活动性心悸,曾入院治疗,但诊治不详,近期再次出现以上症状,面色苍白,无发热,无皮肤出血点,其他体格检查正常。实验室检查:RBC2.8×1012/L,Hb62g/L,MCV74fl,MCH22pg,MCHC0.30,PLT120×109/L,网织红细胞0.012。尿常规正常,肝、肾功能正常;血涂片如图。骨髓象:有核细胞增生活跃,红系增生明显,中幼红细胞占27%,晚幼红细胞占30%,各期红细胞体积均较小,胞核小而致密,胞浆少,边缘不整齐,成熟红细胞以小细胞为主,中心淡染区扩大。骨髓细胞外铁染色阴性,铁粒幼红细胞5%。血清铁蛋白10μg/L。试分析该病例。
参考答案与解析:
-
相关试题
-
男,35岁,1年前曾因发热而服用氯霉素,后头晕,耳鸣,心悸,气短,全身疲乏无力,
-
[单选题,共用题干题] 男,35岁,1年前曾因发热而服用氯霉素,后头晕,耳鸣,心悸,气短,全身疲乏无力,经常发热。查体:唇甲苍白,四肢皮肤有瘀点,心率96次/分。检验:血红蛋白40g/L,白细胞2.5×109/L,红细胞1.50×1012/L,血小板30×109/L。骨髓穿刺显示红细胞和粒细胞增生不活跃,以中晚期细胞为主。该患者最可能的诊断为()A .坏血病B . 缺铁性贫血C . 溶血性贫血D . 再生障碍性贫血E . 急性白血病
- 查看答案
-
男,35岁。1年前曾因发热而服用氯霉素,后头晕,耳鸣,心悸,气短,全身疲乏无力,
-
[单选题,A3型题] 男,35岁。1年前曾因发热而服用氯霉素,后头晕,耳鸣,心悸,气短,全身疲乏无力,经常发热。查体:唇甲苍白,四肢皮肤有瘀点,心率96次/分。检验:血红蛋白40g/L,白细胞2.5×10/L,红细胞1.50×10/L,血小板30×10/L。骨髓穿刺显示红细胞和粒细胞增生不活跃,以中晚期细胞为主。该患者最可能的诊断为()A .坏血病B . 缺铁性贫血C . 溶血性贫血D . 再生障碍性贫血E . 急性白血病
- 查看答案
-
男,35岁,1年前曾因发热而服用氯霉素,后头晕,耳呜,心悸,气短,全身疲乏无力,
-
[单选题,A4型题,A3/A4型题] 男,35岁,1年前曾因发热而服用氯霉素,后头晕,耳呜,心悸,气短,全身疲乏无力,经常发热。查体:唇甲苍白,四肢皮肤有瘀点,心率96次/分。检验:血红蛋白40g/L,白细胞2.5×109/L,红细胞1.50×1012/L,血小板30×109/L。骨髓穿刺显示红细胞和粒细胞增生不活跃,以中晚期细胞为主。该患者适宜下列哪种膳食()。A .低蛋白膳食B . 高铁膳食C . 低能量膳食D . 高盐膳食E . 中医食疗无效
- 查看答案
-
患者,男,60岁,双下肢无力7年。患者7年前无明显诱因出现双下肢疲乏,呈进行性加
-
[单选题,案例分析题] 患者,男,60岁,双下肢无力7年。患者7年前无明显诱因出现双下肢疲乏,呈进行性加重,伴步态不稳,如"脚下踩棉花感"。时作颈项板滞,双上肢沉重、无力。查体:颈椎生理弧度变直,C棘旁压痛,双下肢肌张力增高,膝、踝反射亢进,Hoffmann(+),踝阵挛(+)。X光片示:颈椎退行性变。如对该患者行牵引治疗,牵引的角度是()A .头前屈15°~25°B . 头前屈5°~10°C . 颈部中立位(0°)D . 头后伸0°~15°E
- 查看答案
-
男性,65岁。心悸2年,近1天头晕乏力。患者2年前出现阵发性心悸,活动后明显,可
-
[问答题] 男性,65岁。心悸2年,近1天头晕乏力。患者2年前出现阵发性心悸,活动后明显,可自行好转,无胸痛、恶心呕吐等不适症状。1天前因劳累再发,心悸伴头晕乏力,胸闷,脉搏90次/分。因症状不能缓解入院。除睡眠差外,无多饮多食消瘦,二便正常。无药物和食物过敏史,无烟酒嗜好。高血压10年,最高175/100mmHg。自服硝苯地平血压控制在正常范围内。查体:T36.5℃,P88次/分,R20次/分,BP140/70mmHg。神清,双肺呼吸音清晰,无干、湿啰音。心界向左扩大,心率114次/分,第一心音强弱不等
- 查看答案
-
患者男,36岁,2年前出现无明显诱因的胸前区疼痛,伴劳累后胸闷、心悸、气短1年,
-
[单选题,共用题干题] 患者男,36岁,2年前出现无明显诱因的胸前区疼痛,伴劳累后胸闷、心悸、气短1年,不规则发热1个月,使用头孢唑林钠(剂量不详)后体温恢复正常。查体:体温:38.5℃,胸骨左缘第4肋间触及连续性震颤,闻及4/6级粗糙连续性杂音,P2减弱,毛细血管搏动征、股动脉枪击音阳性。要确诊最有价值的指标是()A .ASOB .胸部X线检查C .ESRD . D.超声心动图E .心电图
- 查看答案
-
男性,60岁,双下肢无力7年。患者7年前无明显诱因出现双下肢疲乏,呈进行性加重,
-
[多选题,案例分析题] 男性,60岁,双下肢无力7年。患者7年前无明显诱因出现双下肢疲乏,呈进行性加重,伴步态不稳,如"脚下踩棉花感"。时作颈项板滞,双上肢沉重、无力。查体:颈椎生理弧度变直,04~6棘旁压痛,双下肢肌张力增高,膝、踝反射亢进,Hoffmann(+),踝阵挛(+)。X光片示:颈椎退行性变。该患者进行颈椎牵引,下列有关注意事项描述不正确的是()A .牵引中应根据患者的反应及时调整体位、重量和时间B . 开始时可以是小重量、短时间,逐渐增加重量和延长时间C . 牵引重量在治疗过程中不能改变
- 查看答案
-
患者女,33岁。主因间断发作性憋气、心悸、头晕、疲乏无力伴手脚麻木6个月入院。既
-
[单选题,案例分析题] 患者女,33岁。主因间断发作性憋气、心悸、头晕、疲乏无力伴手脚麻木6个月入院。既往无心血管病、神经系统病、呼吸系统病史。体检:T37.2℃,P112次/min,R38次/min,BP100/70mmHg。患者呼吸浅快、精神紧张、心率规则、心脏未闻及病理性杂音、呼吸音清晰,双肺未闻啰音,四肢肌张力轻度增高,双手呈内屈状。
- 查看答案
-
男,55岁。心房颤动5年,1年前曾发作语言不利伴肢体活动障碍。该患者长期抗栓治疗
-
[单选题]男,55岁。心房颤动5年,1年前曾发作语言不利伴肢体活动障碍。该患者长期抗栓治疗的药物首选A.阿司匹林B.尿激酶C.低分子肝素D.潘生丁E.华法林
- 查看答案
-
男,55岁。心房颤动5年,1年前曾发作言语不利伴肢体活动障碍。该患者长期抗栓治疗
-
[单选题]男,55岁。心房颤动5年,1年前曾发作言语不利伴肢体活动障碍。该患者长期抗栓治疗的药物首选A.阿司匹林B.尿激酶C.低分子肝素D.潘生丁E.华法林
- 查看答案
